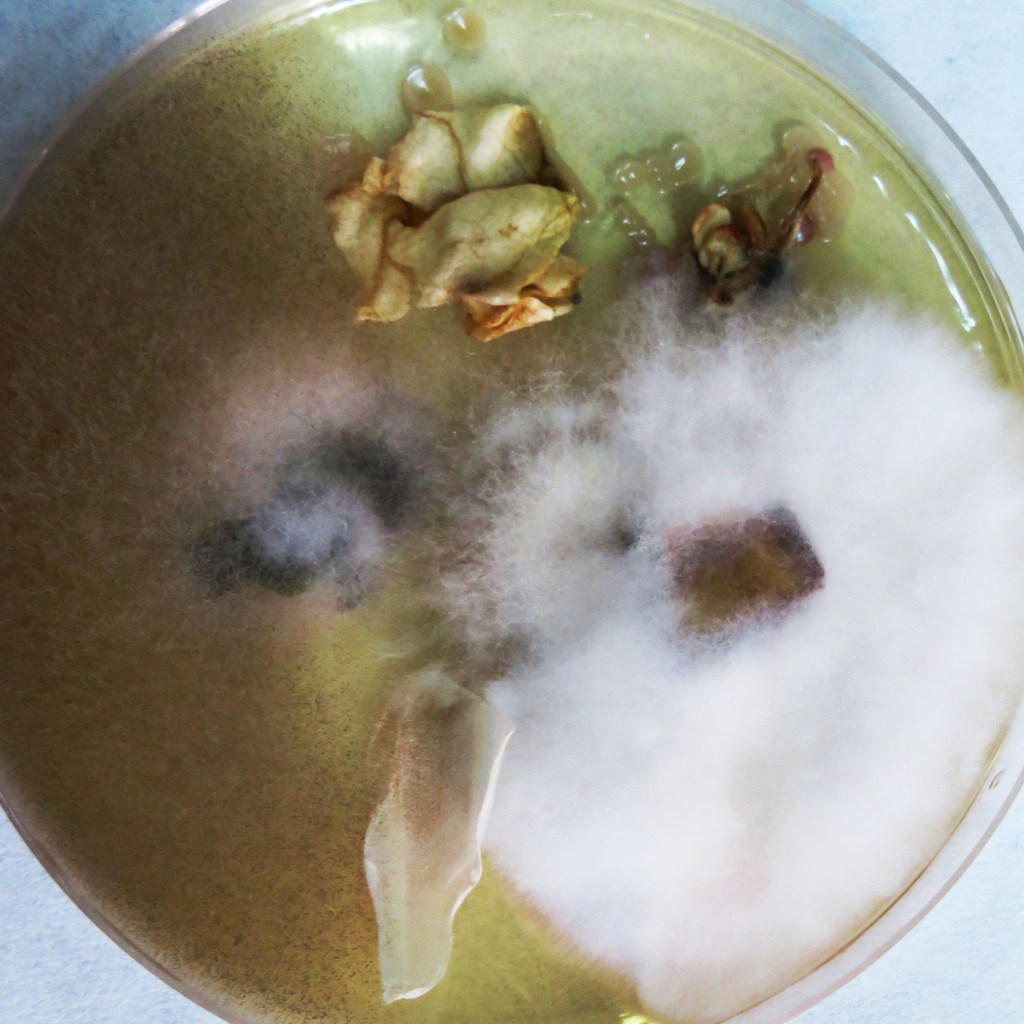
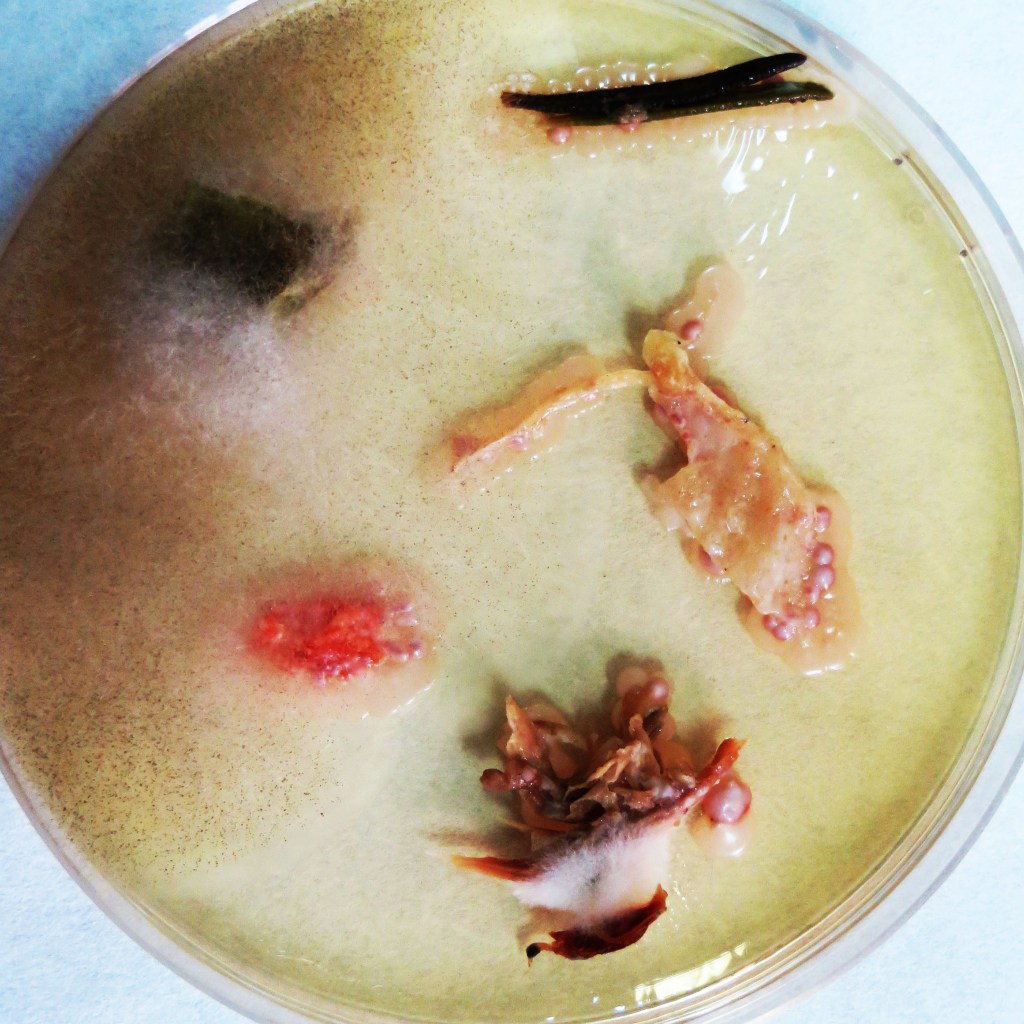

Still life : corps vivant
Still life : corps vivant Kulturlabor Artist in residence Goethe Institut Tunis // Institut Pasteur de Tunis Produced by Goethe Institut 2016 Similar project : https://helalamine.com/2021/01/14/dignity-act-iii-fire/
Experience 1
Experience 2
Experience 3
Experience 4
Experience . 5
Tarte aux citrons
Tarte aux citrons // Test 1 Scanography 2010
Tarte aux citrons // Test 2 scanography 2010
Tarte aux citrons // Test 3 Photography 2010